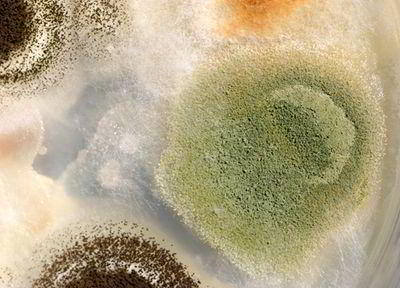
Что вызывает грибок

Как вылечить грибок на ногтях?
Что вызывает грибок?
Грибковые заболевания ногтей вызывают заразные грибы-дерматофиты, разъедающие кожу, волосы и ногти. Опасными для человека и вызывают заболевания, объединенные названием «микозы», являются около 500 из них.
Грибковые заболевания ногтей вызывают заразные грибы-дерматофиты, разъедающие кожу, волосы и ногти. Опасными для человека и вызывают заболевания, объединенные названием «микозы», являются около 500 из них.

Как передается грибок?
Грибок стопы и ногтей — довольно-таки распространенное заболевание, которое передается от человека к человеку при совместном использовании обуви, в бассейнах, общественных банях, педикюрных салонах и других общественных местах. Однако, чаще всего ногтевым грибком заражаются в семье. Передаваясь «по наследству» от старших членов семьи к младшим, грибок поселяется в ногтях, нередко оставаясь там на долгие годы.

Грибок. Что способствует развитию?
Имунная система большинства людей в состоянии справиться с грибком стопы и ногтей, поэтому болезнь у них не развивается. Однако имеются факторы, которые способствуют распространению грибка: длительное ношение неудобной обуви, особенно, изготовленной из синтетических материалов, долгое пребывание кожи стоп во влажной теплой среде, травмы стоп, наличие сосудистых заболеваний и иммунодефицитных состояний, пожилой возраст, прием антибиотиков и оральных контрацептивов.

Грибок и профессии
Самая предрасположенная к грибковым заболеваниям группа — профессиональные спортсмены. Грибком стопы и ногтей поражены многие игроки известных футбольных команд, атлеты и пловцы. Также к группе риска принадлежат служащие военизированных организаций, где в ходу форменная обувь (сапоги и тяжелые ботинки). Те же факторы располагают к грибковой инфекции представителей настоящих «мужских» профессий: сталеваров, шахтеров, рабочих промышленных предприятий, персонал электростанций.

Как распознать грибок?
Обычно грибковое поражение развивается у свободного края ногтя, у боковых краев или у основания (ложа). Больные ногти изменяют форму, цвет (делаются тусклыми, желтыми), утолщаются, затем расслаиваются и крошатся. Вначале грибок поражает один ноготь, потом распространяется дальше или остается неизменным в течение ряда лет. В любом случае без надлежащего лечения грибок всегда ведет к разрушению ногтя.

Грибок ногтей не проходит самостоятельно
Раньше пораженный ноготь считался неизлечимым, и его попросту удаляли. Потому что новый ноготь, который появлялся, также был поражен грибковой инфекцией. Хирургический метод применяется и сегодня, но только при самых тяжелых стадиях болезни.

Как лечат грибок сегодня?
Лечение грибка стоп и ногтей основано на нескольких принципах: устранении факторов, способствующих появлению грибка; применении противовоспалительных мазей; использовании противогрибковых препаратов местного и системного действия (лаки, таблетки). Но даже врач не сразу определяет сколько нужно принимать тот или иной противогрибковый препарат, какие дополнительные методы лечения следует привлечь. Это может быть установлено только в ходе обследования пациента и выяснения особенностей заболевания.

Барьеры в излечении
Для правильного лечения грибка стоп и ногтей необходимо поставить точный диагноз и выявить возбудителя. Вылечить самостоятельно подобное заболевание практически невозможно. Тем не менее, всенародная любовь к самолечению сегодня играет большую роль в распространении заболевания. Нередко даже посетившие врача пациенты, добившись первых результатов, бросают лечение. Болезнь возвращается, и лечение идет по кругу.

Универсальное средство исцеления
Если рассматривать лучшие способы лечения грибка стопы и ногтей, можно встретить очень много рецептов и рекомендаций. Надо сказать, многие современные препараты обладают очень действенным противогрибковым эффектом. При этом не только хорошо уничтожают грибок, но и помогают улучшить состояние самих ногтей. Одним из наиболее эффективных средств этого ряда считается тербинафин.

Секрет тербинафина
Тербинафин может успешно применяться как вовнутрь (в таблетированной форме), так и в качестве наружного средства (спрей). Его основное действие направлено на подавление синтеза веществ, необходимых для развития грибка. Кроме этого, он одновременно губительно воздействует на споры грибковых паразитов, что в полной мере способствует подавлению грибковой инфекции, и очищению организма от возбудителей инфекции.

Важные дополнения
Во время лечения требуется не реже одного раза в месяц обрабатывать зараженные вещи, в том числе обувь, полы, а также все предметы в доме, на которых мог сохраниться грибок. Для этого используют раствор уксусной кислоты или формалина: салфетку, смоченную в растворе, помещают в обувь, обработав предварительно стельки, затем обувь плотно закрывают в полиэтиленовом пакете на сутки.

Профилактика доступная каждому
Старайтесь никогда не надевать чужой обуви (даже домашние тапочки). Ухаживайте за ногами и ногтями. Не носите тесную обувь, не миритесь с потливостью ног. Необходимо либо сменить обувь, либо обратиться к врачу. Если вы посещаете общественные места и знаете, что вам придется ходить босиком — обработайте кожу пальцев и ногти специальными противогрибковыми аэрозолями или спреями. Но лучше всего взять с собой сменную обувь.
По материалам Пульс Плюс









